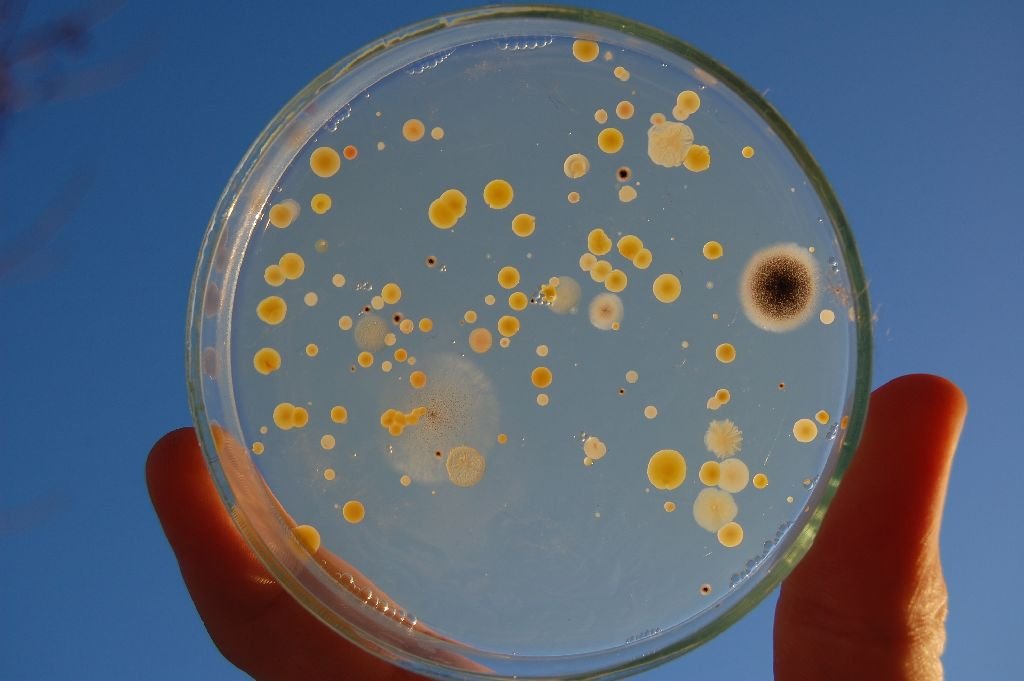

A Sapientia Erdélyi Magyar Tudományegyetem (EMTE) mikrobiológusai, együttműködve a budapesti Eötvös Loránd Tudományegyetem (ELTE) kutatóival, elsőként írtak le Romániából a tudományra nézve új baktériumnemzetséget.
2017. június 06., 00:092017. június 06., 00:09
A Sapientia Erdélyi Magyar Tudományegyetem (EMTE) mikrobiológusai, együttműködve a budapesti Eötvös Loránd Tudományegyetem (ELTE) kutatóival, elsőként írtak le Romániából a tudományra nézve új baktériumnemzetséget.
A Sapientia EMTE csíkszeredai Biomérnöki Tanszékén zajló mikrobiológiai kutatások során környezetmérnök szakos hallgatók a tudomány számára eddig ismeretlen új baktériumnemzetséget illetve fajt tenyésztettek ki és azonosítottak DNS vizsgálatok alapján, dr. Máthé István oktató vezetésével.
Az új nemzetség leírásához szükséges széleskörű biokémiai, molekuláris biológiai vizsgálatokat dr. Felföldi Tamás (ELTE, Budapest) mikrobiológus irányította, az eredményeket pedig rangos tudományos folyóiratban közölték.
A cekendi hulladéklerakó csurgalékvizéből származó új baktérium a Caenimicrobium hargitense nevet kapta. A nemzetségre vonatkozó első névben a latin „caeni” szó a csurgalékvizes reaktor eleveniszapjára utal, ahonnan a baktériumot kitenyésztették, a görög „microbium” szó pedig a magyar mikroorganizmus szó megfelelője. A „hargitense” fajnév a baktérium tágabb származási helyére, a Hargita-hegységre utal.
Három napig állt a bál a kézdiszéki Torján. Pénteken délelőtt kezdődtek és vasárnap este értek véget a Septemberfestre keresztelt falunapok, benne „nemzetközi” főzővetélkedővel és az elmaradhatatlan óriás túrós puliszkával.
Jubileumi kiadásához érkezett Csernáton messze földön híres rendezvénye, amely egyszerre szól hagyományőrzésről, közösségépítésről és szórakozásról. Szeptember 7-én, vasárnap tizedik alkalommal tartanak huszár -és katonadal-találkozót.
Átadta a Kovászna megyei önkormányzat az előkészítő osztályba induló gyerekeknek szánt felszerelt iskolatáskákat. 2250 gyermek részesülhet az ajándékban.
Szeptember 5-7. között zajlanak a 21. alkalommal megrendezett, Septemberfestre keresztelt torjai falunapok. Természetesen idén sem marad el a nemzetközi gasztronómiai verseny és az óriás túrós puliszka. Íme, a program.
Románia legszebb speciális iskoláját vehetik birtokba ebben a tanévben a háromszéki, sajátos nevelési igényű gyerekek: a sepsiszentgyörgyi intézmény egy felújított, kibővített, ultramodern felszereléssel ellátott oktatási egységgé vált.
A parkolási díjak fizetésének tekintetében is halad a korral Sepsiszentgyörgy: jövő hétfőtől csak digitálisan lehet majd fizetni a parkolásért a városban.
A Sepsiszentgyörgyi Helyi Rendőrség, helyi tanácshatározat alapján immáron több éve ellenőrzi a lovas fogatokkal való közlekedést a város területén. Augusztusban újabb, engedéllyel nem rendelkező szekereket foglaltak le.
Sepsiszentgyörgy egyik legnagyobb és legnépszerűbb általános iskolájának diákjai nehéz helyzetben vannak: a tanintézmény mindkét épülete felújítás alatt áll, az osztályokat üggyel-bajjal sikerült elhelyezni. Még egy egész tanévet kell kibírni.
A Mihai Viteazul Főgimnázium épületeinek felújítása akadozik, sportpályáján viszont zajlik a munka: itt épülnek a moduláris tantermek. Sepsiszentgyörgy egyetlen román nyelvű elméleti líceumának diákjai öt év után visszatérnek az intézmény területére.
Kétévente esedékes, immár 23. kollokviumát tartotta a Nemzetközi Címertani Akadémia augusztus 27–30. között Jászvásáron. Ez alkalomból Keöpeczi Sebestyén József erdélyi címerművész munkásságát bemutató tárlatot is berendeztek.
szóljon hozzá!